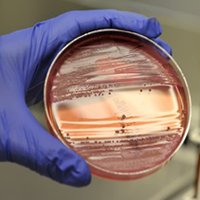
Анализ на бруцеллез Анализ на бруцеллез

Название данной болезни произошло от фамилии первого ученого, который обнаружил вирус бруцеллеза, это произошло еще в далеком 1886 году. Характеризуется эта болезнь тем, что вызвать его может 3 вида микроорганизмов – это:
- те, которые поражают крупный рогатый скот;
- те, которые поражают мелкий рогатый скот;
- те, которые могут быть обнаружены в организме диких животных, таких как зайцы, олени, свиньи и так далее.
Для начала нам необходимо определиться с тем, что такое бруцеллез.
Итак, бруцеллез – это инфекционное заболевание, которое при поражении может вызывать нарушения в работе жизненно важных для человека систем. Это и опорно-двигательная, и сердечно-сосудистая и другие.
Способы и источники передачи инфекции
Заразиться бруцеллезом можно в основном тремя способами, которые несложно выделить:
- Заражение может произойти бытовым способом, если у человека на коже или слизистой имеются повреждения, которые непосредственно и контактируют с зараженным.
- Второй – самый распространенный способ передачи данного вируса – это фекально-оральный, можно объяснить на примере, когда человек употребляет в пищу продукты зараженные этим вирусом, это могут быть сыры, молоко или мясо больного животного.
- Воздушно капельным путем также можно заразиться, если контактировать с больным.
Возбудитель заболевания – это вирус бруцелла, источником которого являются животные, эти микробы находятся в их моче, крови, фекалиях, при контактировании с ними человек подвергается опасности заразиться, особенно, если у него на теле имеются повреждения, через которые собственно и происходит заражение.
Отметим, что человек, который является носителем данного вируса, не опасен для других людей, поскольку не может стать для них источником вируса.
Попасть в организм человека вирус может не только при контактировании с больным животным, но и в тех случаях, когда в пищу употребляются продукты, полученные от зараженного скота.
Если возбудитель бруцеллеза уже попал в организм, то он с большой скоростью распространяется по всем системам.
Врачи отмечают, что бруцеллез является инфекционным заболеванием, вызываемым бактериями рода Brucella. Основные признаки заболевания включают лихорадку, потливость, усталость, боли в мышцах и суставах. Симптомы могут проявляться постепенно, что затрудняет диагностику на ранних стадиях. Важно отметить, что бруцеллез может привести к серьезным осложнениям, если не начать лечение вовремя.
Лечение заболевания обычно включает антибиотики, такие как доксициклин и рифампицин, которые назначаются на длительный срок. Врачи подчеркивают, что важно соблюдать полный курс терапии, чтобы избежать рецидивов. Профилактика бруцеллеза заключается в соблюдении санитарных норм при работе с животными и их продуктами, а также в вакцинации скота. Врачи призывают население быть внимательными к симптомам и обращаться за медицинской помощью при подозрении на инфекцию.

Особенности течения болезни
При попадании в организм человека вирус находиться от одной до четырех недель и при этом не причиняет особого вреда и не подает никаких признаков присутствия. Эта болезнь также характерна тем, что однозначно нельзя сразу по симптомам определить, что имеет место именно бруцеллез. Поэтому специалисты выделяют несколько типов течения заболевания, каждый из которых имеет симптомы и другие особенности, например, срок протекания болезни:
- Острая форма данной патологии длится до полутора месяцев.
- Подострая, длительность которой составляет уже до четырех месяцев.
- Хроническая стадия имеет длительность более четырех месяцев.
- Особенным случаем является развитие резидуальной стадии данной патологии.
Бруциллез КРС – это заболевание, которое присуще крупному рогатому скоту. Заражение скота происходит при контакте с больным животным. Самыми основными поражениями у животных являются поражения половой системы, также важно отметить, что летальные случаи являются очень редкими.
В скотоводческих хозяйствах обычно знают, что делать при возникновении ситуаций заражения животных бруцеллезом, иногда больных животных изолируют из стада, так что каждому скотоводу очень важно знать, что такое бруцеллез.
Симптомы бруцеллеза у человека
У человека симптомы заболевания имеют различия, которые можно разделить на подгруппы по типу протекания болезни, то есть в зависимости от стадии, которые мы рассмотрели немногим раньше.
- Если говорить об острой форме течения заболевания, то она характеризуется следующими симптомами:
- Отсутствие аппетита.
- Головные боли.
- Бессонница.
- Температура тела может повышаться до 40 градусов.
- К общим симптомам можно отнести слабость, озноб, раздражительность, боли в мышцах.
- Далее рассмотрим симптомы, которые наблюдаются при подострой форме течения заболевания. При этой форме заболевания можно наблюдать резкие перепады температуры тела, ощущение постоянной жажды, но аппетит при этом или очень плохой или вообще отсутствует, также характерно ощущение боли в мышцах, костях и суставах. Также как и при острой форме, наблюдается бессонница, раздражительность, озноб и другие симптомы.
- Хроническая форма бруцеллеза характеризуется более серьезными осложнениями, которые касаются нервной системы, опорно-двигательного аппарата, половой системы человека. Могут наблюдаться разные гормональные сбои и другие патологии.
- Резидуальный бруцеллез характеризуется тем, что изменения в организме происходят более серьезного плана, это касается центральной и вегетативной нервной системы.
Лечение данного заболевания рекомендуется начать на начальном этапе его развития, таким образом можно избежать некоторых опасных для здоровья и жизни человека последствий.
Диагностика такого заболевания, как бруцеллез, происходит только после того, как пациент посетит врача, после консультации и сдачи некоторых анализов можно говорить о том, что имеет место именно бруцеллез.
После того, как специалист поставил диагноз бруцеллез, необходимо незамедлительно начать лечение.
Подробнее о симптомах бруцеллеза у человека.
Бруцеллез — это инфекционное заболевание, вызываемое бактериями рода Brucella, которое передается от животных к человеку. Люди, столкнувшиеся с этой болезнью, часто описывают свои симптомы как схожие с гриппом: высокая температура, потливость, усталость и боли в мышцах. Многие отмечают, что заболевание может проявляться в хронической форме, что затрудняет диагностику и лечение. Важно, что бруцеллез может вызывать серьезные осложнения, такие как артрит или проблемы с сердцем.
Лечение обычно включает антибиотики, но многие пациенты подчеркивают, что процесс восстановления может занять много времени. Некоторые люди делятся опытом о том, как важна ранняя диагностика и соблюдение профилактических мер, особенно для тех, кто работает с животными. Обсуждая свои переживания, они призывают к вниманию к симптомам и необходимости обращаться к врачу при первых признаках заболевания.

Лечение
Первое, что необходимо отметить, это то, что все методы лечения подразумевают немедленную госпитализацию больного в стационар. Лечение проводится строго под наблюдением врача. Анализ на бруцеллез подразумевает прохождение некоторых диагностических методов, это анализ крови и спинномозговой жидкости и другие диагностические методы.
Первым назначением врача-специалиста будет прохождение бактериальной терапии. Около двух недель необходимо будет принимать рифампицин и доксициклин. Также одновременно применяются некоторые противовоспалительные препараты по назначению врача.
Для того чтобы поддержать иммунитет во время лечения бруцеллеза у людей, применяют также препараты для повышения защитных сил организма.
Все назначения врача в большей степени зависят от формы протекания болезни бруцеллеза и особенностей самого организма человека.
Если заболевание принимает хроническую форму, то применяются такие методы лечения, как УВЧ и парафиновые аппликации. Этот метод лечения может предполагать нахождение больного на курортном лечении.
Для того чтобы избежать или некоторым образом уменьшить риск заболевания данной болезнью, рекомендуется соблюдать некоторые профилактические меры.
Профилактика
Если имеются риски заболевания данным недугом, то при ситуации, когда возникают некоторые признаки бруцеллеза необходимо незамедлительно обратиться к специалисту. Все профилактические меры могут быть направлены на предотвращение контактов с больными животными, если это не представляется возможным, то нужно в обязательном порядке проводить меры для того, чтобы предотвратить заболевание животных.
Рекомендуется делать прививки против бруцеллеза, причем данное мероприятие касается не только человека, но и всех животных.
Прогнозы
Если говорить о своевременном лечении, то важно отметить, что больной имеет намного больше шансов вернуться к здоровой жизни без патологий. Однако, если лечение не начать своевременно на начальном этапе, то в несколько раз увеличивается риск стать инвалидом, поскольку заболевание может принять хроническую форму. Если же заболеванию подвергается женщина в положении, то беременность не будет иметь положительных сторон, поскольку имеет место самопроизвольный аборт, рождение мертвого ребенка или преждевременные роды. Заболеть бруцеллезом во время беременности – это очень опасно как для самой женщины, так и для ее не рожденного малыша.
После прохождения курса лечения могут наблюдаться некоторые осложнения, которые могут быть на фоне патологий со стороны нервной системы или опорно-двигательного аппарата. Для каждого человека, который имеет непосредственный контакт с животными, очень важно знать про бруцеллез и какие симптомы при нем бывают.
Важно также отметить, что под наблюдением врачей больной будет находиться на протяжении двух лет.

Вопрос-ответ
Что такое бруцеллёз и чем он опасен для человека?
Бруцеллез – особо опасная инфекционная болезнь животных и людей, сопровождающаяся лихорадкой, поражением сердечнососудистой, нервной, мочеполовой систем, органов репродукции и особенно часто опорно-двигательного аппарата. Наиболее часто бруцеллезом болеют домашние животные (козы, овцы, коровы, свиньи).
Как лечить бруцеллез у коров?
В санитарных (СП 3.1.085-96) и ветеринарных (ВП 13.3.1302-96) правилах Россельхознадзора однозначно сказано, что поголовье в зараженном бруцеллезом хозяйстве подлежит полной ликвидации. Таким образом, болезнь не лечится, и все меры должны быть направлены на недопущение распространения бруцеллеза.
Советы
СОВЕТ №1
Обратите внимание на симптомы. Бруцеллез может проявляться различными симптомами, такими как высокая температура, потливость, усталость и боли в суставах. Если вы заметили у себя или у близких подобные признаки, не откладывайте визит к врачу.
СОВЕТ №2
Проводите профилактические меры. Если вы работаете с животными или на ферме, соблюдайте правила гигиены и используйте средства защиты. Регулярно проходите медицинские осмотры, чтобы выявить заболевание на ранней стадии.
СОВЕТ №3
Следите за качеством продуктов. Избегайте употребления непастеризованного молока и молочных продуктов, так как они могут быть источником инфекции. Приобретайте продукты только у проверенных производителей.
СОВЕТ №4
Соблюдайте курс лечения. Если вам поставили диагноз бруцеллез, строго следуйте рекомендациям врача и завершите курс антибиотиков, даже если симптомы исчезли. Это поможет предотвратить рецидив заболевания.
